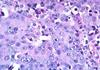

Lung and Pleural Tumors - Gupta Flashcards
(86 cards)
example of a benign lung tumor
Hamartoma
how does hamartoma appear on X-ray?
“coin lesion” rounded, well circumscribed, peripheral, solitary

what is the definition of Hamartoma?
nodules of mature** connective tissue (often cartilage)
for hamartomas - are they congenital or a neoplasm?
evidence supports neoplasm
What is this? and describe it

Pulmonary Hamartoma
grey-white glistening nodule grey tinged = cartilage
What is this? describe

Harmatoma
lobules of mature, benign cartialge with entrapped benign respiratory epithelium
compare death rates of lung cancer and breast cancer in women
more women now die each year from lung cancer than breast cancer in the US
where does lung cancer rank as far as cancer mortality?
is most common cause of cancer mortality worldwide
what percentage of lung cancers occur in smokers or ex-smokers?
87%
what is the increase risk for lung cancer in 1 ppd smokers? 2 ppd smokers?
1 ppd = 10 fold increased risk 2 ppd = 60 fold increased risk
what is the second most common cause of lung cancer in the US? (besides tobacco smoke)
Radon
besides radon and cigarettes, what are some other common causes of lung carcinoma?
Industrial hazards - radiation, uranium Asbestos Air pollution
what is the relationship between smoking and asbestos exposure for lung cancer? what types of carcinoma?
asbestos exposure is synergistic w/ smoking 50-90 times greater risk in asbestos workers who smoke inc risk for adenocarcinoma (bronchiogenic carcinoma) NOT mesothelioma
for primary lung carcinoma, what are the 4 histologic classifications? (the 4 main types of lung cancer)
Adenocarcinoma
Squamous cell carcinoma
Large cell carcinoma
Small cell carcinoma
For small cell carcinoma, when does the pt usually present? what treatment options are available? prognosis?
Usually presents at an advanced stage - very aggressive, usually have mets before presenting tx options = chemotherapy +/- radiation NOT surgical candidates
for Non-small Cell Carcinoma, what are the treatment options? how does this compare to small cell carcinoma? prognosis?
NSCLC is more resistant to traditional chemotherapy than small cell
Tx options: surgery, +/- chemotherapy/radiation
much better prognosis
what is the most common histologic type of lung carcinoma, especially for non-smoker and female smokers
adenocarcinoma
where do most adenocarcinomas of the lung usually arise? how can you help remember this?
peripherally adenocarcinoma is most common histologic type in female smokers - females smoke filtered cigarettes - have to draw in harder to get puff - gets smoke further more distally into lungs - peripheral
Goljan: filters filter out the big particles, small particles make it deeper down in the bronchial tree - further out to periphery
Adenocarcinoma - what is the appearance (differentiation)? production of what? growth pattern?
glandular differentiation
mucin production *
lepidic growth sometimes pneumonia-like consolidation
what is lepidic growth?
grows along the alveoli - snaking a long
What is this? and describe

Pulmonary Adenocarcinoma - CT
spiculated peripheral mass
what is this? and describe

lung adenocarcinoma
peripheral location
What is this? and describe

Lung Adenocarcinoma
occasional pneumonia-like consolidation of entire lobe
What is this? and describe

Lung Adenocarcinoma
mucin-producing glandular structures